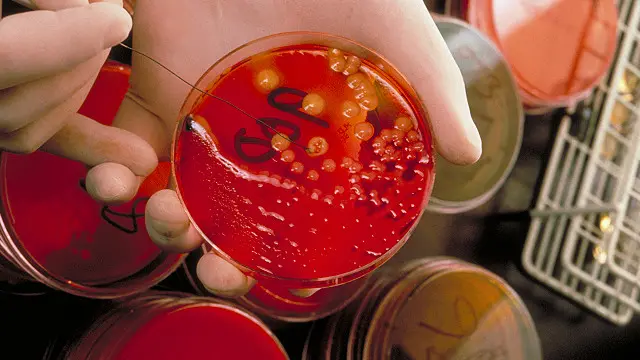
ایڈز اور ایچ آئی وی کی ویکسین اور ادویات کے آنے سے اب یہ ایک ایسا مرض بن گئی ہے جو ساری عمر کا انفیکشن تو ہے مگر موت کا فوری پروانہ نہیں

کیا ایچ آئی وی کے علاج میں انقلابی تبدیلی آ گئی ہے؟

،تصویر کا ذریعہGetty
- مصنف, جیمز گیلگر
- عہدہ, ہیلتھ ایڈیٹر، بی بی سی نیوز ویب سائٹ
ان دنوں بہت ہی پرجوش باتیں جاری ہیں کہ ایچ آئی وی کی وبا کو کنٹرول کرنے میں معاملات ایک بڑی تبدیلی لانے والے مرحلے تک پہنچ گئے ہیں۔
یہ کوئی علاج یا ویکسین نہیں مگر اس بیماری کے وائرس کو منتقل کرنے سے روکنے کا انتہائی موثر طریقہ ہے۔
اس کے پیچھے خیال یہ ہے کہ ایچ آئی وی کی ادویات ہم جنس پرست مردوں کو دی جائیں جو بغیر تحفظ کے جنسی تعلق قائم کرتے ہیں اور انہیں ابھی تک وائرس نے متاثر یا انفیکٹ نہیں کیا ہے۔
اس کا مطلب یہ ہے کہ دوا جسم میں موجود ہو گی اور وائرس کے آنے کی منتظر ہو گی کہ جیسے ہی وہ جسم میں داخل ہو وہ اس کا خاتمہ کر سکے۔
یہ طریقۂ کار اب تک اس شعبے میں کی جانے والی بڑی دریافتوں میں سے ایک پر انحصار کرتا ہے جسے اینٹی ریٹروویل ادویات یا آر این اے وائرس کے ایک وسیع گروہ کی انسدادی ادویات کہا جاتا ہے۔
ایچ آئی وی کا انفیکشن جب 1980 میں دریافت ہوا تو یہ موت کا پروانہ تھا جو کہ افریقہ میں اس سے قبل دہائیوں تک بغیر سامنے آیا اموات کا ذمہ دار رہا تھا۔
ہر مریض اس وائرس کے لگنے کے بعد مرض کا شکار ہوتے ہوتے ’ایکوائرڈ امیونوڈو ایفیشنسی سینڈروم‘ یا ایڈز کی جانب بڑھتا تھا جس کے بعد موت لازم ہو جاتی تھی۔
مگر اگر آپ 1990 کے اواخر میں متعارف کروئی جانے والی ادویات کے اثرات کا جائزہ لیں تو آپ کو اندازہ ہو گا کہ ایڈز کے نتیجے میں اموات بڑے پیمانے پر کم ہوئیں۔
End of سب سے زیادہ پڑھی جانے والی
ایچ آئی وی انفیکشن اب ایک یقینی قاتل سے زندگی بھر کا انفیکشن بن چکا ہے کم از کم مغرب میں ایسا ہے جہاں ادویات دستیاب ہیں۔

،تصویر کا ذریعہAFP
ان ادویات نے در حقیقت ایک ’انقلابی تبدیلی‘ کے مرحلے پر لا کر کھڑا کیا ہے اور ایسے افراد جنہیں یہ انفیکشن ہو اُن کی تعداد میں اضافہ اپنی ذات میں ایک مسئلہ ہے جس سے اس وائرس کے پھیلاؤ کا خطرہ ہمیشہ سے موجود رہتا ہے۔
تصور کریں کہ ہر آٹھ میں سے ایک جنسی ساتھی ایچ آئی وی کے وائرس کا شکار ہو یہ لندن میں ہم جنس پرست مردوں کو درپیش مسائل میں سے ایک ہیں اور باقی برطانیہ میں یہ عدد 26 میں سے ایک ہے۔
اسی وجہ سے ایک مرد نے مجھے بتایا کہ اسے لندن میں ایچ آئی وی کا شکار ہونے کا زیادہ خطرہ ہوتا ہے اور اس سے اس کے تعلقات بنانے کے عمل پر شدید برا اثر پڑا ہے۔
بہت سے لوگ کہیں گے کنڈوم کیوں نہیں استمعال کرتے جو کہ ایچ آئی وی کے پھیلاؤ کے روکنے کے موثر ہتھیار ہیں اور ہر جنسی صحت کے ماہر کی جانب سے تجویز کیے جاتے ہیں۔
مگر آپ کو پتا ہے کہ بہت سے صحت کے پیغامات جیسا کہ سگریٹ نوشی نہ کریں، ورزش زیادہ کریں، شارب کم پئیں نظر انداز کیے جاتے ہیں ایسے ہی کنڈوم کے استعمال کو بھی نظر انداز کیا جاتا ہے جس میں ایک جائزے سے پتا چلا کہ صرف 55 فیصد مردوں نے کسی دوسرے مرد کے ساتھ آخری بار جنسی تعلقات قائم کرتے ہوئے کنڈوم کا استعمال کیا تھا۔
کچھ ایسے ہیں جو اچھے رشتوں میں بندھے ہیں جبکہ کچہ ایسے ہیں جو بہت شی مشکلات کا شکار ہیں۔
برطانیہ میں ہم جنس پرست افراد ایڈز کا شکار ہونے والے گروہ میں سب سے بڑا گروہ ہے جن میں ہر سال 2500 افراد اس کا شکار ہوتے رہے ہیں گذشتہ ایک دہائی کے دوران اور انہیں سب سے زیادہ خطرہ درپیش ہے۔
،تصویر کا ذریعہScience Photo Library
برطانیہ کے میڈیکل ریسرچ کونسل اور پبلک ہیلتھ انگلینڈ کے تجربات نے ظاہر کیا کہ ایچ آئی وی کا شکار ہونے والے مردوں کو ادویات کی فراہمی کے نتیجے میں 86 فیصد انفیکشن میں کمی واقع ہوئی ہے۔
اس بات میں کسی بات کا شک نہیں کہ یہ بہت بڑی تبدیلی ہے اور اگر ہم یہ بات ایک دوا کے حوالے سے کرتے جو 86 فیصد کینسرز کا خاتمہ کرے تو ہم اسے ایک معجزاتی دوا کہتے۔
اس تحقیق نے ظاہر کیا ہے کہ ایچ آئی وی کو ہر 13ویں مرد کے لیے ختم کیا جا سکتا ہے اگر اسے ایک سال تک زیرِ علاج رکھا جائے۔
اس تحقیقاتی ٹیم کے ایک رکن نے اس کی ایک انتہا درجے کی مثال دی یہ کہتے ہوئے کہا کہ ’اگر یہ دوا تمام مردوں کو دی جائے اور تمام اس کے استمال کا اہتمام کریں تو ہم اس وبا کو ختم کر سکتے ہیں۔‘
مگر ان ادویات کو کبھی بھی اس پیمانے پر کبھی بھی تجویز نہیں کیا جائے گا مگر ان کے استمال کے نتیجے میں یہ امکان موجود ہے کہ سینکڑوں نئے انفیکشن کو روکا جا سکتا ہے جہاں کوئی اور دوا کام نہیں کرتی اسی لیے اسے ایک گیم چینجر یا حالت کا پانسہ پلٹنے والی دوا کہا جا رہا ہے۔





















